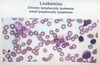

PNH
(Proximal Nocturnal Hemoglobinuria)
Triad of hemolytic anemia, hypercoagulability, and pancytopenia
acquired mutation in the PIGA gene
associated deficiency of CD55 and CD59 complement inhibitor proteins
PNH results in impaired synthesis of Glycosylphospatidylinositol (GPI), resulting in inability to anchor DAF (CD55) & CD59 to the cell membrane and loss of inhibition of complement-mediated lysis of erythrocytes, leukocytes & platelets.
Hyper IgE Syndrome
Defective JAK-STAT signaling → impaired Th17
↓ Neutrophil proliferation/chemotaxis
Eczema
Abscesses (ie, cold) (eg, Staphylococcus, Candida)
Recur sinopulmonary infections
Dysmorphic facies (eg, broad nose, prominent forehead)
Retained primary teeth
↑ IgE
Eosinophilia
“ F A T E D “
Facies (dysmorphic), Abcesses(cold), Teeth(retained primary teeth), Eosinophila & inc IgE, Dermatological findings(Eczema).
SLE
Positive ANA, anti–double-stranded DNA, anti-Smith Antibodies
Skin & Joints:
Malar rash.
Arthritis
Cardiovascular manifestations of SLE:
accelerated atherosclerosis.
verrucous (Libman-Sacks) endocarditis.
Renal involvement in SLE:
(Nephritis or nephrotic Syndrome)
diffuse proliferative glomerulonephritis (characterized by proliferative and necrotizing lesions with crescent formation during active disease).
Light microscopy also classically shows diffuse thickening of the glomerular capillary walls with “wire-loop” structures due to subendothelial immune complex deposition
Osteoarthritis
Onset >40; increases with age
Knees,Hips,DIP joint1st CMC joint
Morning stiffness None/brief (<30 min)
No systemic Involvement
Hard, bony enlargement of joints
Rheumatoid arthritis
Onset 40-60; often younger
MCP, PIP, Wrists
Prolonged Morning Stiffness
Systemic Symptoms: Fever, Fatigue, Weight loss
Soft/spongy, warm joints
Acute rheumatic fever
Endemic in developing countries
Occurs 2-4 weeks after acute group A streptococcal pharyngitis
Molecular mimicry: Anti-streptococcal antibodies attack cardiac & neuronal antigens
Acute/subacute
Migratory arthritis
Pancarditis (mitral regurgitation)
Sydenham chorea
Chronic
Mitral stenosis
Note:
Rupture of Chordae tendonae causes mitral regurge.
“ J ❤️ N E S “
J = Joints (polyarthritis)
❤️ = Myocarditis / MVP
N = Nodes (subcutaneous nodule over bony
prominence)
E = Erythema Marginatum
S = Sydenham Chorea (antibody mediated destruction of corpus straitum of basal ganglia)
Acute Kidney Injury
(Pre-Renal)
Caused by decr renal perfusion;
BUN/creatinine ratio typically >20:1
Fractional excreti Na+ <1%
Urine osmolality >500 mOsm/kg
Microscopy Hyaline casts
Acute Kidney Injury
(Post-Renal)
Caused by urinary tract obstruction with normal nephron capacity. Etiologies include bilateral calculi, enlarged prostate, or a renal tumor in an individual with a sole functional kidney.
Bilateral Hydronephrosis is also seen.
Acute Kidney Injury
(Intra Renal)
Aka Acute Tubular Necrosis
Renal ischemia (eg, hemorrhage, sepsis) or nephrotoxins (eg, aminoglycosides, radiocontrast)
Can also present in setting of cardiac ischemia due likely episode of Hypotension.
BUN/Cr Typically ~10-15
Fractional excretion Na+ >2%
Urine Osm ~300 mOsm/kg
Microscopy Muddy brown casts
Auto immune hepatitis
Female > male
Associated other autoimmune disorders
Hepatocellular injury (↑ transaminases)
Anti–smooth muscle & Antinuclear Antibodies
Histology: Interface hepatitis (portal & periportal lymphoplasmacytic infiltrate)
Primary biliary cholangitis
Female»_space; male
Asossiated other autoimmune disorders
↑ alkaline phosphatase , ↑ Bilirubin
Autoimmune destruction of intralobular bile ducts.
Complication includes Cirhosis & Liver failure
Malnutrition
Bile aids in absorbtion of Fat-Sol vitamins thus patient can have Deficiency of Fat sol vitamins( A,D, E &K)
Antimitochondrial & Antinuclear Antibodies
Histology: Florid duct lesion (granulomatous destruction of small bile ducts)
Primary sclerosing cholangitis
Male > female
Asossiated with IBD (particularly UC)
↑ alkaline phosphatase
± p-ANCA*
Histology: Fibrous obliteration of bile ducts with concentric periductal deposition of connective tissue (onion skin–like pattern )
LSD
Fabry Disease
XLR Only LSD that is XLR all others are AR
α-Galactosidase A Deficiency Globotriaosylceramide accumulated
Angiokeratomas
Peripheral neuropathy
Glomerulopathy
LSD
Tay-sachs
AR
β-Hexosaminidase A deficiency
GM2 (ganglioside) accumulation
Macular cherry-red spot (Cherry Red Macula)
Progressive neurodegeneration
LSD
Gaucher Disease
AR
β-Glucocerebrosidase deficiency
Glucocerebroside accumulation
Hepatosplenomegaly
Pancytopenia
Bone pain/osteopenia
LSD
Niemann-Picks disease
AR
Sphingomyelinase Def
Sphingomyelin accumulation
Macular cherry-red spot
Progressive neurodegeneration
Hepatosplenomegaly (Not seen in tay-sachs)
LSD
Krabbe disease
AR
Galactocerebrosidase Def
Galactocerebroside & psychosine accumulation
Progressive neuro degeneration
Peripheral neuropathy
Optic atrophy
LSD
Metachromatic leukodystrophy
AR
Arylsulfatase A Def
Cerebroside sulfate accumulation
Progressive neurodegeneration
Peripheral neuropathy
Reye Syndrome
Acute liver failure
Hepatomegaly
Elevated transaminases; coagulopathy
Rapidly progressive encephalopathy
Vomiting, lethargy, seizures, coma following salicylate (aspirin) administration in children.
Aspirin-induced mitochondrial dysfunction causes impaired fatty acid metabolism and microvesicular steatosis of the liver
Carcinoid syndrome
Diarrhea, Flushing, Wheezing
– Carcinoid Heart Disease (Right sided endcardial fibrosis and thickening of heart valves secondary to exposure to serotonin)
– Vitamin B3 deficiency (Pellagra > Diarhea, Dermatitis, Dementia), Vit-B3 def is because Tryptophan which is also a precursor for Vit-B3 gets shunted more towards production of serotonin therefore Vit-B3 level decrease.
– Elevated 24-hr urinary excretion of 5-HIAA.
– Octreotide for symptomatic patients.
Li-Fraumeni syndrome
TP53 Mutation
Autosomal dominant
Caused by inactivating mutation in corresponding tumor suppressor gene
Deletion of remaining normal allele (second hit) leads to loss of heterozygosity & malignant transformation
Sarcomas, Breast cancer, Brain tumors, Adrenocortical carcinoma, Leukemia
Von Hippel-Lindau syndrome
VHL gene mutation (chromosome 3).
- Hemangioblastomas
- Clear cell renal carcinoma
- Pheochromocytoma
Familial adenomatous polyposis
APC gene mutation
Colorectal cancer
Desmoids & osteomas
Brain tumors
Lynch syndrome
Autosomal dominant
Inherited DNA mismatch repair defect
MSH2, MLH1, MSH6, PMS2 genes
Colorectal cancer
Endometrial cancer
Ovarian cancer
Patient with postive family history are at risk should start colonscopy by age 5